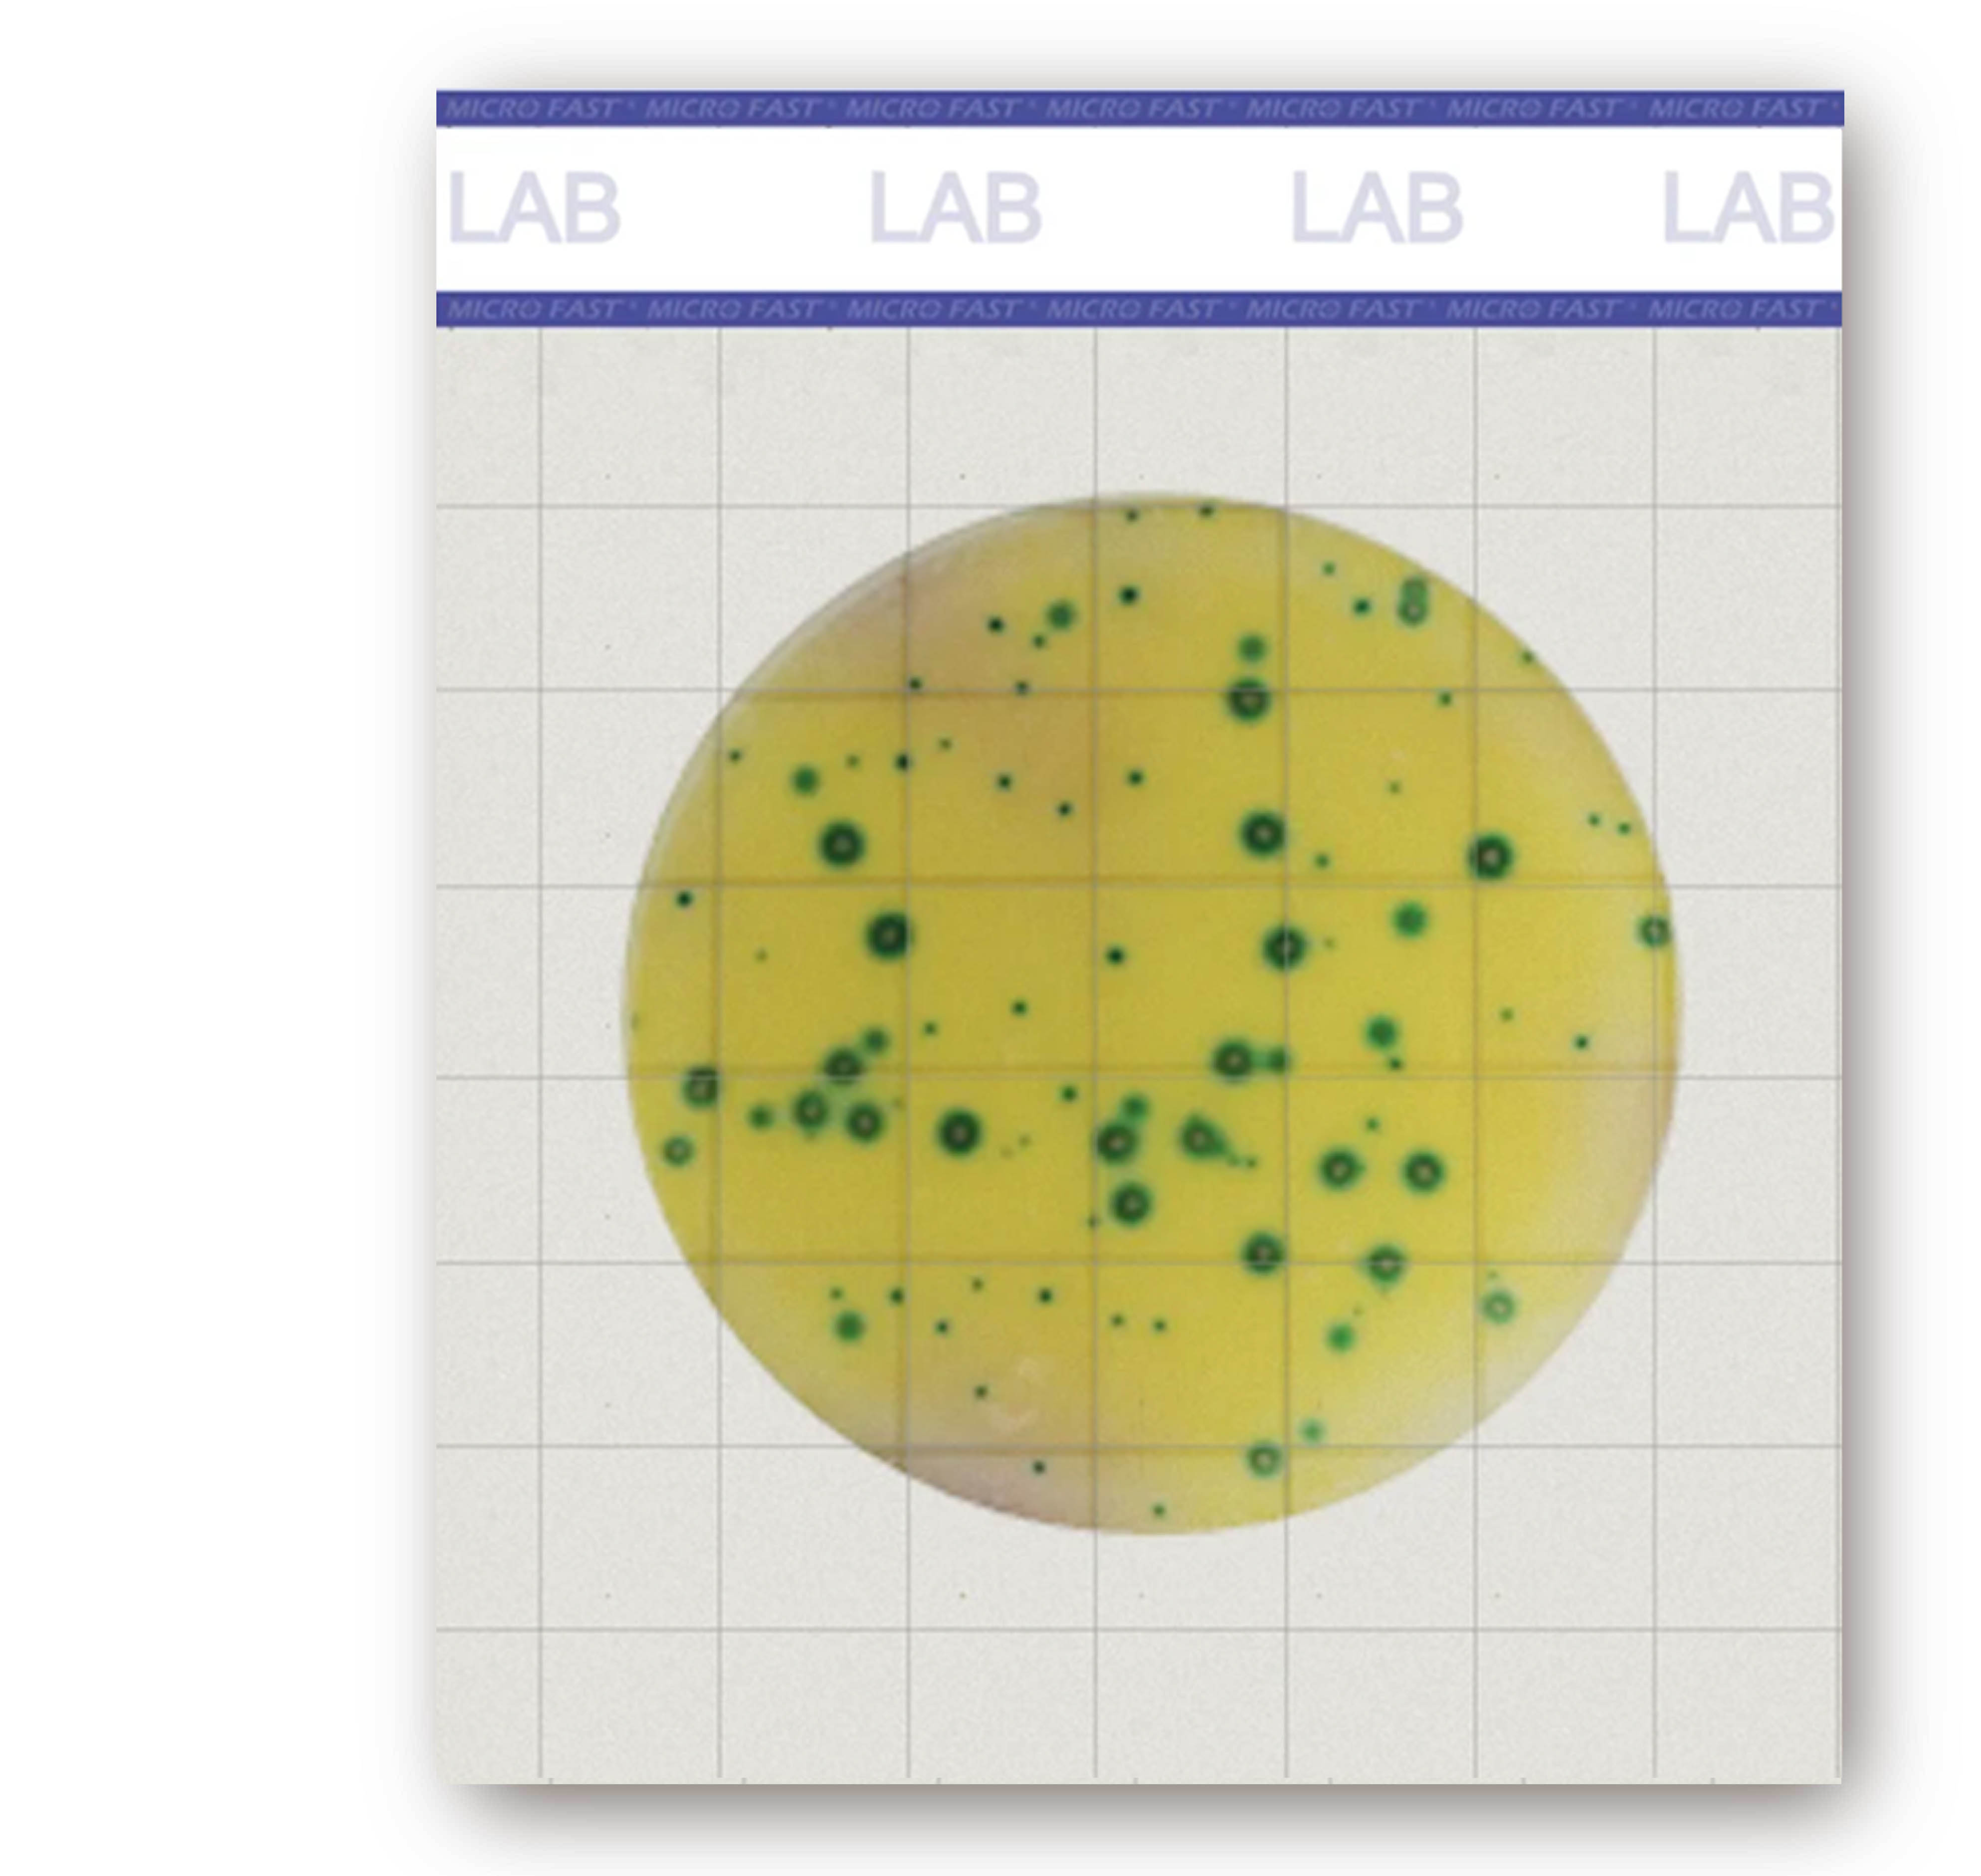

PRODUCTS
微生物快檢片
LAB Premium 乳酸菌數測試片
PerkinElmer-MicroFast- 特點
- 通過AOAC國際認證
- 符合ISO9001品質管理系統
- 省去培養基配置流程
介紹
檢測項目:乳酸菌數適用樣品:食品、食品原料及環境….等各式微生物檢測
規格:25片/包
MicroFast ® LAB Premium 乳酸菌數測試片
Lactic Acid Bacteria Count
乳酸菌檢測片是一種樣品即用型培養基系 統。它使用創新的技術,如快速擴散系統和新一 代微生物著色技術,以實現菌落的快速增殖和解 釋,大大提高了實驗室的檢測效率。
MicroFast®乳酸菌數(Lactic Acid Bacteria Count,簡稱LAB)快檢片為預製型培養基,採用創新的冷水凝膠技術和新一代的微生物顯色技術,能夠讓菌落快速增殖並顯現顏色,並省去傳統培養基配置流程,製程符合ISO9001品質管理系統,產品通過美國AOAC國際公定分析化學家協會認證,適用於各類食品、食品原料及環境...等中乳酸菌數的測定。
●培養溫度: 36±1℃
●培養時間: 48±1hr
●菌落判讀: 藍綠/藍菌落數
國際專業產品檢驗認證
國際公定分析化學家協會認證(AOAC-RI)AOAC-RESEARCH INSTITUTE
License No. 032103
操作步驟
1、將測試片平放在實驗台上,緩慢掀開上膜。
2、將1mL檢液垂直加入培養基的中心區域。
3、緩慢蓋上上膜,避免產生氣泡。。
4、將 MicroFast 專用壓板放置在測試片的中心位置。
5、輕觸壓板中心位置,使樣品均勻地擴散分佈在測試片上。
6、將測試片透明面向上,正置於培養箱中,依照對應條件培養,測試片堆叠培養時,不宜超過20片。

2、將1mL檢液垂直加入培養基的中心區域。
3、緩慢蓋上上膜,避免產生氣泡。。
4、將 MicroFast 專用壓板放置在測試片的中心位置。
5、輕觸壓板中心位置,使樣品均勻地擴散分佈在測試片上。
6、將測試片透明面向上,正置於培養箱中,依照對應條件培養,測試片堆叠培養時,不宜超過20片。

儲存條件
1、未開封時,最佳儲存溫度為2℃-8℃,並在有效期限內用完。
2、在濕度較高的環境下,請將測試片恢復至室溫再使用。
3、開封後,需將鋁箔袋對折兩次,用膠帶黏貼或用封口夾密封,避光保存於2℃-8℃,並在一個月內用完。
4、短期儲存貨運輸時,可短暫將測試片置於室溫。
2、在濕度較高的環境下,請將測試片恢復至室溫再使用。
3、開封後,需將鋁箔袋對折兩次,用膠帶黏貼或用封口夾密封,避光保存於2℃-8℃,並在一個月內用完。
4、短期儲存貨運輸時,可短暫將測試片置於室溫。
注意事項
1、揭開上膜時,不要觸碰培養基檢測區域。
2、請勿使用已污染的測試片。
3、測試片需正置培養,且疊放片數不宜超過20片。
4、請將測試片避光保存。
5、使用後的測試片存在二次污染的可能性,請高壓蒸氣滅菌後再按照相關法律法規處理。
2、請勿使用已污染的測試片。
3、測試片需正置培養,且疊放片數不宜超過20片。
4、請將測試片避光保存。
5、使用後的測試片存在二次污染的可能性,請高壓蒸氣滅菌後再按照相關法律法規處理。